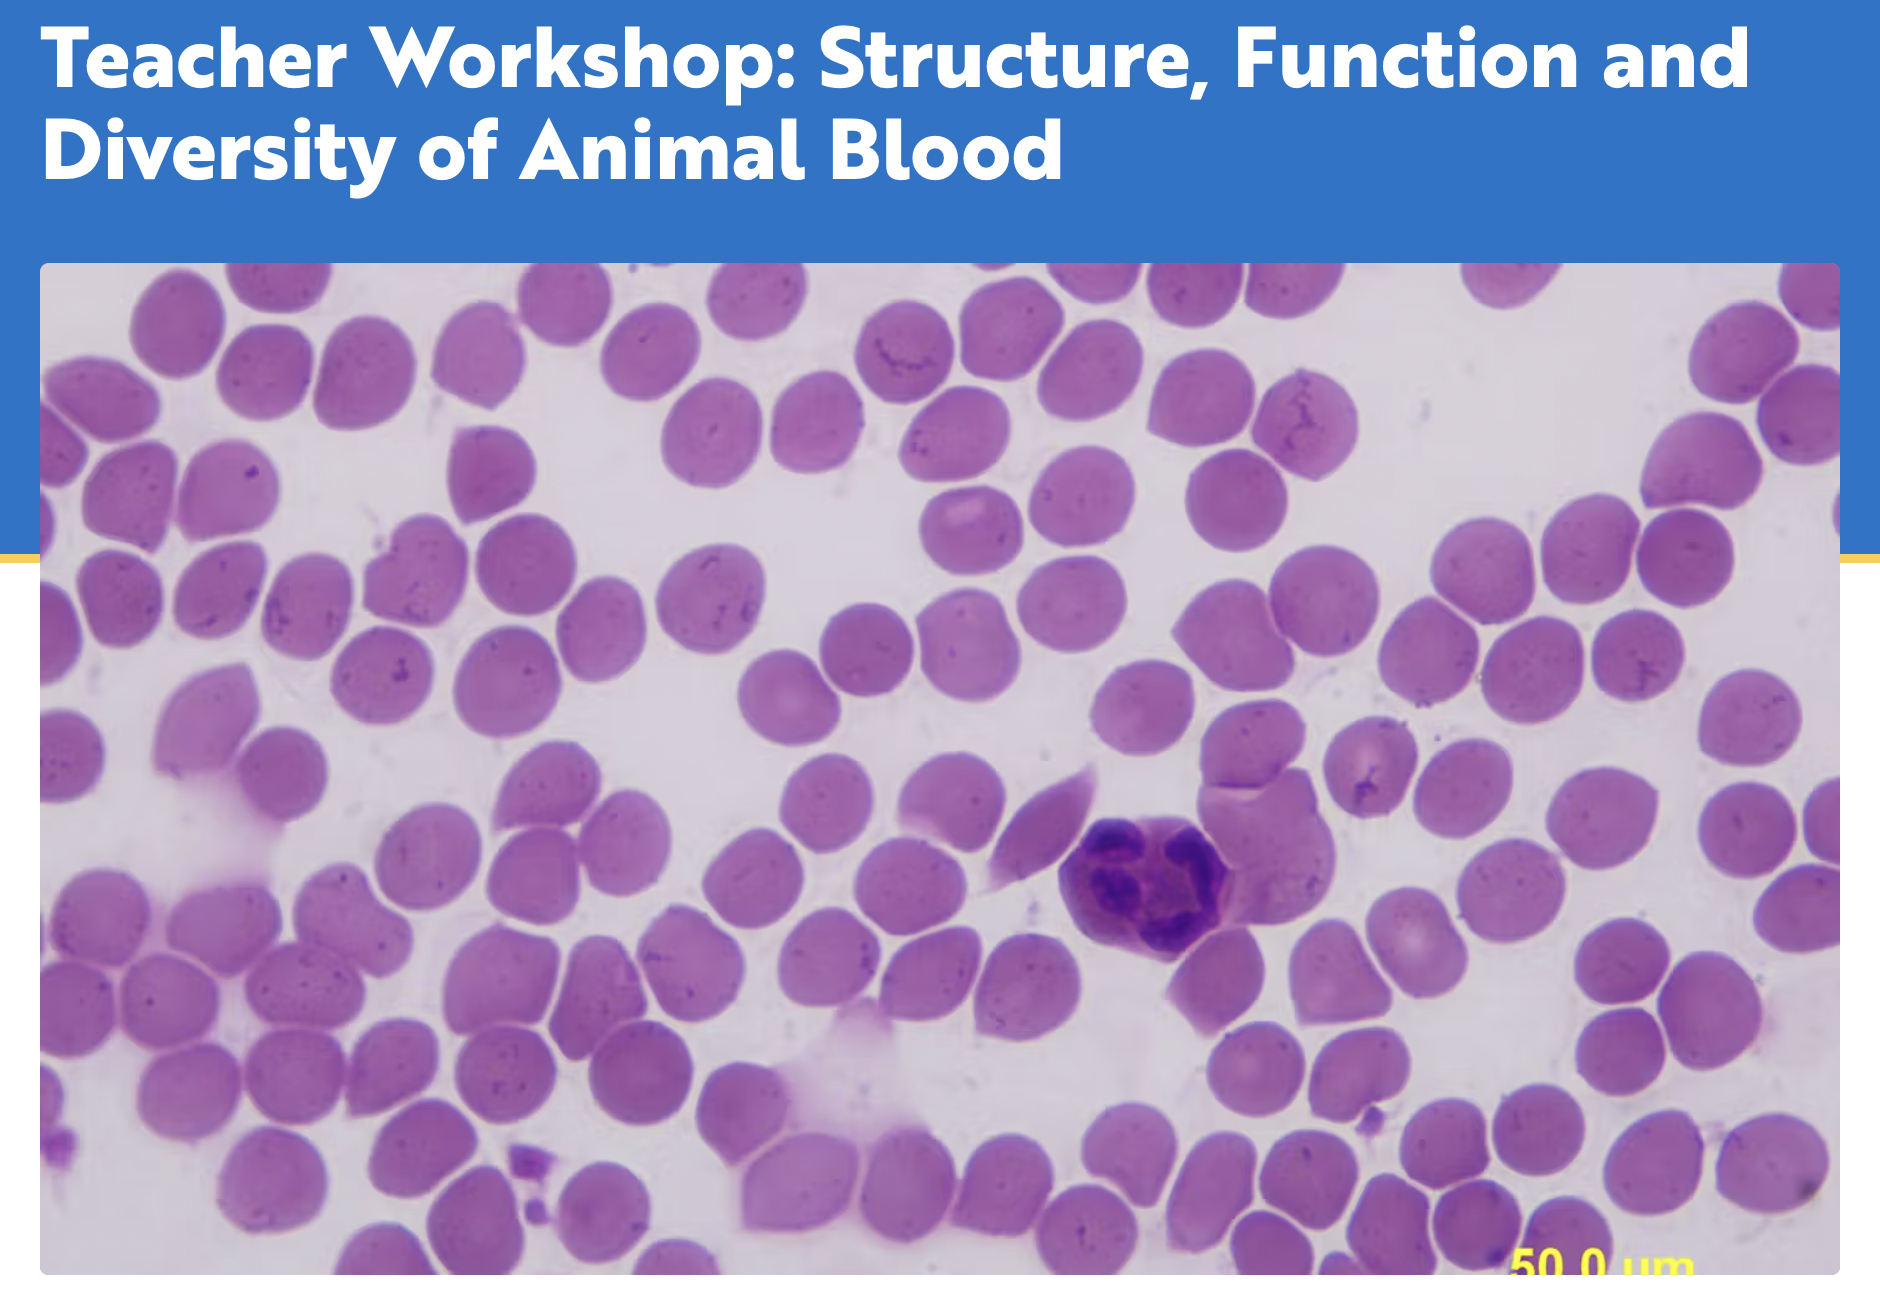

Shedd Aquarium: Teacher Workshop
Teacher Workshop (Virtual, Zoom): Structure, Function, and Diversity of Animal Blood Date & Time: Thursday, March 14, 2024 4:30 p.m. – 6 p.m. Grades: 3-12 Educators Price: $25.00 per Educator Additional: 1.5 ISBE Clock Hours Available
0 Comments